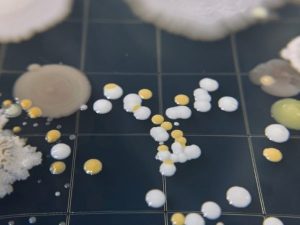

先日頂いたメロンが固めだったので、追熟して食べごろを待つことにしました。ところが2日ほどして見ると、カビが生えているではありませんか!

白いふわふわとしたカビ、黒いススのようなカビがあって、ところどころ緑のカビも見えます。このメロン、食べられるのでしょうか?
カビが生えたのは、ヘタの付け根の皮の部分です。丸ごと捨てるのはさすがにもったいないですよね。カビの部分を厚めにカットして、中身はぜひ食べたいのですが…。
そこでメロンにカビが生えてしまったときの対処法などを、詳しく調査しました。
- メロンに生えるカビの種類を調査!画像でカビの見た目もチェック
- メロンにカビが生えたときの対処法とは?
- メロンにカビが生える原因と間違って食べてしまった場合の注意点
- カビ以外でメロンが食べられない(腐った)ときの見分け方
- カビを防止してメロンを長持ちさせる保存方法
カビの中には毒性のあるものや、アレルギーにつながるものがあると聞いたことがあります。
カビが生えた後の対処法などはもちろん、カビを生やさずに美味しく食べるための保存方法もしっかり調査してご紹介していきます。
早速ご一緒に、確認していきましょう!
目次
メロンのカビは食べられる?黒や白など色別に見分け方や対処法を調査!
メロンに生えるカビの種類を調べると、ご紹介しきれないほどの種類が存在することがわかりました。

代表的なカビの色と特徴を、簡単にご紹介します。
| カビの色 | 特徴 | 食べられるか |
| 白 | ・毒性が強い可能性アリ | × |
| 黒 | ・毒性が強い可能性アリ ・毒性が弱い種類でもアレルギー症状が出る可能性アリ |
|
| 緑 青 |
・毒性が強い可能性アリ ・毒性が弱い場合もある |
|
| 赤 | ・毒性が強い可能性アリ |
同じ色でも毒性や特徴が違う全く別のカビという場合があります。
中には毒性が弱いカビもありますが、素人がカビ毒について正しく判断するのは難しいので、カビは食べられないと覚えておくのが安全です!
*毒性が強いカビを食べてしまった場合の危険性については、後ほど「メロンの皮・ヘタ・中身などにカビが生える原因!もしも食べてしまったら? 」で詳しくご紹介します。
では、実際にどのような見た目のカビが生えるのかを画像でチェックして、カビが生えてしまったときの対処法も確認してきましょう。
メロンに生えるカビの種類を紹介!画像で見た目もチェック
カビが生え始めのときは「ゴミ?カビ?」と見分け方が難しい場合がありますが、基本的には下記のような異変を感じたらカビです。
ゴミとカビの見分け方
- メロン周辺が、鼻を近づけなくてもカビ臭い(*カビを直接吸い込むのは危険なので、ご注意下さい)
- 異変を感じる部分が柔らかくなっている、ヌルヌルしている など

実際にメロンがカビた画像をご紹介しますので、色などの見た目をチェックしてみましょう!
カビの画像が苦手な方は、こちらをクリックすると画像を飛ばせます。
白いふわふわしたカビ
↓メロンの皮に白カビがびっしりと生えています。
金がないから親からの仕送りめっちゃ嬉しいw
メロンがカビてました pic.twitter.com/eWVaRQRTvT
— いっつー (@tabisuruinukkor) June 19, 2016
↓カットメロンを購入して、食べている途中でカビに気づいたようです。
【悲報】食べてたメロンカビてた pic.twitter.com/PNFeht5DFg
— もちねこ (@Mochi_N_Game) March 16, 2020
黒いカビ
↓つる(ヘタ・茎)の部分に、びっしりと黒いカビが生えていますね。
まじかよ。。実家に郵便局のお中元カタログで送ったメロンにカビ生えてた。しかも、なまものでゆうパッククール便じゃないんかい。母がコールセンターに電話したら明日またかけてくださいとか意味わからん。 pic.twitter.com/qLQm7NHMQR
— は る ま き * (@mw_ma_haru) July 28, 2019
緑のカビ
↓こちらはかなり状態が悪いですね。断面を見ると、果肉の種の方まで緑・黒・白のカビが生えています。
まっ 待て 静かに……! これを見てくれ
メロンにカビが生えてる pic.twitter.com/EC7nklMXso
— うみゃ / umya (@umya1011) August 9, 2019
赤(ピンク)のカビ
↓このメロンは、おしり(底の方)に赤のカビが生えています。
ゆーきにわたすつもりやったメロン
カ、カビが、、、 pic.twitter.com/MJ1lSKZ8VJ— 樹* (@bboy_yorosyuuni) June 25, 2015
カビが生えたメロンは丸ごと捨てる!?対処法を紹介
カビが生えたメロンを丸ごと捨てるべきか、カビの部分を取り除いて食べてもいいのかを迷うことと思います。
対処例をご紹介するので、食べられるかを判断する参考になさってみて下さい。
まだカットしてないメロンの皮にカビが生えた
カビの根まで取り除くために、カビの部分から3〜5センチを切り取るようおすすめします。
*表面に見えるカビの部分を洗うだけでは、カビの根まで取り除くことができません。
カット後のメロンにカビが生えた
カビが生えたカットメロンは、丸ごと捨てるのがおすすめです。タッパーなどに入れたカットメロンの一部にカビが生えた場合は、カビが生えていない部分のメロンも全て捨てるのが一番安全です。
カビは、増殖して集合体になることで私達の目に見える状態になります。目には見えないカビの胞子が飛んで他の部分にも付着している可能性があるので、慎重に判断なさって下さい。

妊娠中の方、赤ちゃん、アレルギー体質の方など
体調に気をつける必要がある状況の方がカビの生えたメロンを食べるのは、おすすめできません。
特に免疫力が低い方は、少量の菌が体に入っただけでも腹痛などの食中毒やアレルギーの症状が出る危険性を考えて、厳しく判断なさって下さい。
カビの生え始めには、目に見えなくても皮がカビ臭いなどと感じることもあります。いつもと違うと感じたときは、ご自分の五感を信じて食べるかどうかを決めて下さいね。
とはいえ、「怪しいな」と思いながら食べて後から後悔するなんてこともあると思います。次に、もしカビが生えたメロンを食べてしまったら、どうしたらいいのかをご紹介します。
メロンの皮・ヘタ・中身などにカビが生える原因!もしも食べてしまったら?
メロンを通販でお取り寄せすると、「追熟してから食べて下さい」と説明書きが同封されていることがあります。指示通りに追熟している間にカビが生えると、ショックですよね。

メロンにカビが生える原因は、下記のとおりです。先程画像をご紹介した色別にチェックしてみて下さい。
| カビの色 | 原因 |
| 白 | 空気中のどこにでもいる菌。湿気が多くて温かい場所で簡単に増殖 |
| 緑・青 | |
| 黒 | 湿気が多い場所に生えやすい |
| 赤 | 収穫前に畑の土から付着 |
万が一カビを食べてしまっても、下記のような異常な食べ方をしない限り、体に影響が出ないことが多くあります。まずは安静にして様子をみて下さい。

- 毎日カビを食べ続ける
- 一度に異常な量のカビを食べる
- 妊娠中の方、赤ちゃんなどが一度に大量にカビを食べる
ただし毒性が極度に強いカビの場合は、体に入れる量によって発がん性などの危険性もあります。食べる前に必ずカビのチェックをし、食べられるかを慎重に判断していきましょう。
メロンを食べて食中毒やアレルギーのような症状が出た場合は、可能であれば下記の点に注意して病院を受診なさって下さい。医師が原因を特定しやすくなりますよ。
- 食べてしまったメロンの残りを病院に持っていく
- 可能であれば嘔吐物や便の一部を病院に持っていく

バラ色カビ病とは、メロン・いちご・トマトなど湿度が高いビニールハウス内で栽培する植物に発生しやすい病気です。
バラ色カビ病のカビは「子どもが食べてしまって嘔吐が止まらなくなった」という口コミもあるほど強い毒性を持っているので、ご注意下さい。
外側を見ただけではわかりにくい場合もあるのですが、メロンの見た目や味に下記のような異変を感じたら、丸ごと捨てて下さいね。
- 苦い(舌がしびれるほど苦味を感じることもある)
- 果肉が割れて、その部分にカビが生えている
- 表面にピンクやオレンジのカビが生えている
メロンは、他にも「うどん粉病」(葉っぱに白いカビがつく病気)などにかかる場合があります。栽培なさる方は、その都度対処が必要です。
メロンに生えるカビの種類や危険性についてご紹介してきましたが、カビが生えなくてもメロンが腐ってしまうことがありますよね。
次にメロンが腐って食べられなくなったときの見分け方もご紹介します。腐ったメロンを食べた場合にも体調を崩すことがあるので、カビと同様に要チェックです!
メロンは腐るとどうなるの?カビ以外の目安や見極め方がコレ!
メロンって、食べごろの見極めが難しいですよね。少しでもタイミングをはずすと味がぼやけますし、腐るのも早いです。

メロンが下記のような状態になったら腐っているので、食べないで下さい!
*カビ以外の症状をご紹介します。
腐ったメロンの見分け方
- 果肉が柔らかすぎる、水っぽい
- 種が黒くなっている
- 甘い臭いが強くて生ゴミのような臭いも感じる
- 食べると酸味がある
- 舌がピリピリする(炭酸のような感じ)
- 歯ごたえがなく溶けるようにドロっとした食感

メロンの食べごろを見極める方法は、こちらです。
- 皮をむかなくてもメロンの甘い香りがする
- おしりを優しく触ると、少しやわらかい
- メロンの皮を指ではじくと、水分が詰まっている証拠に低い音がする
上記のような状態になったら、食べる3時間ほど前に冷蔵庫に入れて、冷やして食べましょう!
メロンは水分が多い&栄養価が高い果物なので、保存環境によってすぐに傷んでしまいます。せっかくのメロンを早く傷めないよう、最後に正しい保存方法も確認しましょう!
カビ防止できるメロンの保存方法は?温度や場所の注意点や日持ち期間
高温でジメジメした場所にメロンを置くとすぐに傷むことは予想できるのですが、「日持ちが長くなる最適な保存方法は?」と聞かれると、正しい答えを知りません。
そこで丸ごとメロンとカット後のメロンに分けて保存方法を調査しました。保存中の注意点や日持ち期間と一緒にご紹介していきます。

丸ごとメロンの保存方法
メロンを丸ごと買うと、追熟が必要な場合が多いですよね。カビ対策をしながら保存するポイントは2つです。
- 追熟中は風通しのいい場所で常温保存(温度は高くても25℃が目安)
- 完熟になったら冷蔵庫保存(追熟が進むのを止めるため)
日持ちは買った時点でどれだけ熟しているかによって変わります。先程ご紹介した食べごろの見極め方を参考に、判断してみて下さい。
カットメロンの保存方法
カットしたメロンはすぐに味が落ちてしまうので、日持ちは長くても3日です。
- メロンをカットし、種を取る
- 食べやすい大きさに切り分ける
- 【半分など大きくカットした場合】は切り口にラップをし、【一口大にカットした場合】は清潔な保存容器に入れて、冷蔵庫に入れる
- 保存中、保存容器のフタに水滴がついたら拭き取る

メロンをカットすると、切り口に空気中、調理器具、手指などから雑菌が付着するのは避けられません。
カビ防止のために食べる分だけ保存容器から出し、食べない分はすぐに冷蔵庫に戻して下さいね!
まとめ
メロンに生えるカビの特徴などを確認し、カビを防止して保存する方法までご紹介してきました。
ポイントをまとめてみます!
- メロンに生えたカビは食べられないと覚えておくのが安全
- カビの状態によっては、カビの部分を大きく切り取って食べられる場合もある
- カビの菌は生活空間のどこにでもいて、温度や湿度によって増殖が早くなる
- カビの中には強い毒性を持つ種類もあるので注意が必要
- カビ以外にも、メロンが腐って食べられなくなることがある
- 丸ごとのメロンは、完熟前後で保存場所が違う
- カット後のメロンは日持ちが短い
メロンに生えるカビの色は黒、白、緑、赤などで、種類は無数にあることがわかりました。毒性が無いカビもありますが、素人が見た目だけで判断して食べるのは危険です。
カビの部分は基本的に食べられない、カビが見えなくても状態によっては丸ごと食べられない場合もあると覚えておいて頂けると幸いです。
また、栄養豊富なメロンにカビの菌が付着すると、保存環境によっては短い期間で増殖してしまうことがあります。
間違って食べてしまった場合は、少量なら慌てる心配がない場合もありますが、体に異変が出た場合はすぐに病院を受診なさって下さいね。
ご紹介した保存方法も参考に、カビを防止しながら美味しくメロンを食べきっていきましょう!


